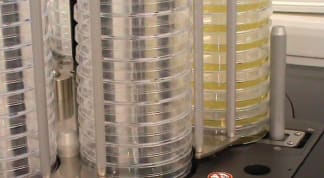

The T1030sc thermal imaging camera from FLIR Systems (Wilsonville, OR) features hardware, software, and a 1024 × 768 HD-IR detector. High-fidelity images are created using FLIR’s OSX™ Precision HDIR optics, which include an ultrasonic autofocus capability.
The T1030sc thermal imaging camera from FLIR Systems (Wilsonville, OR) features hardware, software, and a 1024 × 768 HD-IR detector. High-fidelity images are created using FLIR’s OSX™ Precision HDIR optics, which include an ultrasonic autofocus capability.
The T1030sc offers a thermal sensitivity of less than 20 mK (NETD), and wide temperature operating ranges with calibrations up to 2000 °C. The FLIR OSX™ Precision HDIR Optical System features an ultrasonic drive, ambient temperature drift compensation, and parasitic radiation protection.
An integrated on-board Vision™ processor combines FLIR’s patented MSX® multi-spectral dynamic imaging with a series of other proprietary image enhancement algorithms. Users of the T1030sc are able to view, acquire, analyze, and share data with FLIR’s advanced ResearchIR Max software, or by using MathWorks® MATLAB. A high-speed interface enables the T1030sc to stream uncompressed and unfiltered raw data at 60Hz, 120Hz, and 240 Hz frame rates, as well as enable digital I/O communication.
For Free Info Click Here

